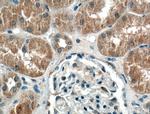
SPOCD1 Antibody in Immunohistochemistry (Paraffin) (IHC (P))

Search
Proteintech
SPOCD1 Polyclonal Antibody
{{$productOrderCtrl.translations['antibody.pdp.commerceCard.promotion.promotions']}}
{{$productOrderCtrl.translations['antibody.pdp.commerceCard.promotion.viewpromo']}}
{{$productOrderCtrl.translations['antibody.pdp.commerceCard.promotion.promocode']}}: {{promo.promoCode}} {{promo.promoTitle}} {{promo.promoDescription}}. {{$productOrderCtrl.translations['antibody.pdp.commerceCard.promotion.learnmore']}}
产品信息
22243-1-AP
种属反应
宿主/亚型
分类
类型
抗原
偶联物
形式
浓度
规格
纯化类型
保存液
内含物
保存条件
运输条件
产品详细信息
Immunogen sequence: PAAPTKALP CLPPWEGVLD MFSIKRFRAR AQLVSGHSCR LVQALPTVIR SAGCIPSNIV WDLLASICPA KAKDVCVVRL CPHGARDTQN CRLLYSYLND RQRHGLASVE HMGMVLLPLP AFQPLPTRLR PLGGPGLEVT HSSLLLAVLL PKEGLPDTAG SSPWLGKVQK MVSFNSKVEK RYYQPDDRRP NVPLKGTPPP GGAWQQSQGR GSIAPRGISA WQRPPRGRGR LWPEPENWQH PGRGQWPPEP GLRQSQHPYS VAPAGHGFGR GQHFHRDSCP HQALLRHLES LATMSHQLQA LLCPQTKSSI PRPLQRLSSA LAAPEPPGPA RDSSLGPTDE AGSECPFPRK A (854-1204 aa encoded by BC114430)
仅用于科研。不用于诊断过程。未经明确授权不得转售。
生物信息学
蛋白别名: protein phosphatase 1, regulatory subunit 146; SPOC domain-containing protein 1; unnamed protein product
基因别名: PPP1R146; SPOCD1
UniProt ID: (Human) Q6ZMY3
Entrez Gene ID: (Human) 90853